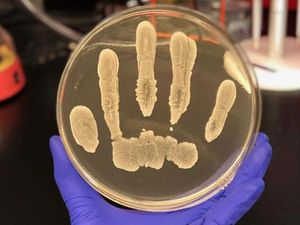
Supporting image for story

Scientists have found a cancer-fighting chemical in human skin bacteria
The believe Staphylococcus epidermidis may help to protect against skin cancer.
A type of bacteria found on healthy human skin produces a chemical that may help protect against skin cancer, scientists have found.
Tests on mice have shown that a strain of the microbe Staphylococcus epidermidis can inhibit the growth of skin cancer by generating a substance known as 6-N-hydroxyaminopurine (6-HAP).
The scientists say their discovery highlights the importance of the microbiome – the community microbes found on and in the body – in preventing disease and boosting health.
Study author Dr Richard Gallo, of the University of California, San Diego, said: “There is increasing evidence that the skin microbiome is an important element of human health.

In the experiments, the mice were exposed to two types of S. epidermidis – one had the capability to produce 6-HAP while the other did not.
The rodents were then exposed to cancer-causing ultraviolet rays (UV). Those with the bacteria on their skin that did not make 6-HAP had many skin tumors, but mice with the S. epidermidis strain producing 6-HAP did not.
On later injecting the mice with 6-HAP, the team found it was not harmful.

When melanoma cells were transplanted into the mice, the animals which had received 6-HAP intravenously saw their tumours shrink by more than half compared to those that did not receive the substance.
The team says while it appears the S. epidermidis strain may add a layer of protection against skin cancer, they aren’t certain about the role 6-HAP plays and further research is needed to determine whether it actively prevents cancer or if loss of 6-HAP increases cancer risk.
The study is published in the journal Science Advances.





